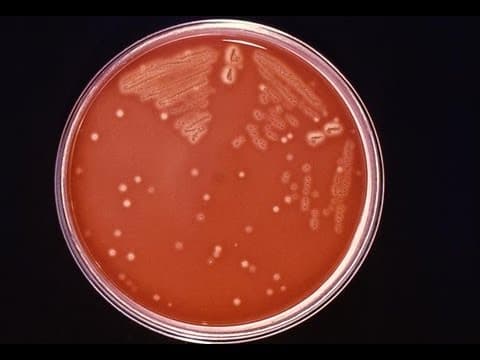
Infekcija sa streptokokom grupe A "ozbiljan" rizik za majku

Novorođenčad majki oboljelih od koronavirusne infekcije izgledaju zdravo, bez kliničkih znakova COVID-19, rezultat je praćenja trudnica u Wuhanu, Kina.
Na početku pandemije COVID-19, malo se znalo o infekcijama dojenčadi i djece i njihovoj kliničkoj slici. Dr. Yalan Liu i kolege s Medicinskog fakulteta u Tongji, Sveučilište Huang zhong u znanosti i tehnologiji u Wuhanu opisuju klinički tijek četvoro donešene novorođenčadi čije su majke imale koronavirusnu infekciju tijekom trećeg tromjesečja, objavljeno je u znanstvenom časopisu Frontiers in Pediatrics.
Troje novorođenčadi rođeno je carskim rezom uslijed zabrinutosti zbog simptomatske infekcije majke; četvrto dijete je porođeno vaginalnim putem. Sva su djeca bila izolirana od majke odmah nakon rođenja. Svi su imali ocjenu Apgara 7-8 u prvoj minuti života i nakon 5-minute Apgar ocjene 8-9.
Troje testirane dojenčadi imalo je negativan rezultat obriska na COVID-19 u uzorcima brisa grla 72 sata nakon rođenja; roditelji četvrtog djeteta odbili su testiranje. Dvoje novorođenčadi bilo je zdravo i klinički normalno, a dvoje je imalo prolazne osipe koji su se spontano riješili. Jedno novorođenče je razvilo prolaznu tahipneju koja je zahtijevala nazalni kontinuirani pozitivan pritisak u dišnim putovima, ali je disanje postalo redovito u roku od tri dana. Dijete je hranjeno umjetnim mlijekom tijekom 5 dana, a otpušteno je iz neonatalne intenzivne njege 7. dana. Sve četiri bebe dobro su napredovale uz prehranu umjetnim mlijekom pri zadnjem pregledu.
Ovi nalazi, zajedno s ranijim izvješćem, ukazuju na to da je vertikalni prijenos COVID-19, ako se pojavi, rijedak.
U Kini je zabilježen slučaj slučaja neonatalne infekcije COVID-19, 36 sati nakon rođenja, ali ostaje nejasno je li to slučaj vertikalnog prijenosa s majke na dijete.
Dr. David A. Schwartz s Medicinskog fakulteta u državi Georgia u Augusti, koji je nedavno pregledao moguće ishode majki i novorođenčadi iz SARS-CoV-2, uzročnika lijeka COVID-19 je rekao: "U ovom trenutku evolucije pandemije SARS-CoV-2, čini se da trudnice s COVID-19 nisu izložene riziku za prijenos virusa na svoj plod tijekom 3. tromjesečja. Međutim, i dalje je malo informacija ili ih nema na raspolaganju o učincima koronavirusnih infekcija koje su se pojavile u ranoj trudnoći. "
"Prema mojoj analizi velikog broja trudnica zaraženih koronavirusom i njihove novorođenčadi, koja će uskoro biti objavljena u Arhivu patologije i laboratorijske medicine, časopisa College of American Pathologists, nije došlo do smrti majki i još uvijek nema potvrđenih slučajeva intrauterinog prenošenja virusa na plod ”, rekao je. "Također nisam upoznat s potvrđenim slučajevima intrauterinog prijenosa iz osobne komunikacije s mojim kolegama u Kini i drugdje."
SOURCE: http://bit.ly/39TXKDa
Clinical Infectious Diseases, online March 12, 2020.
Dr. Vesna Harni